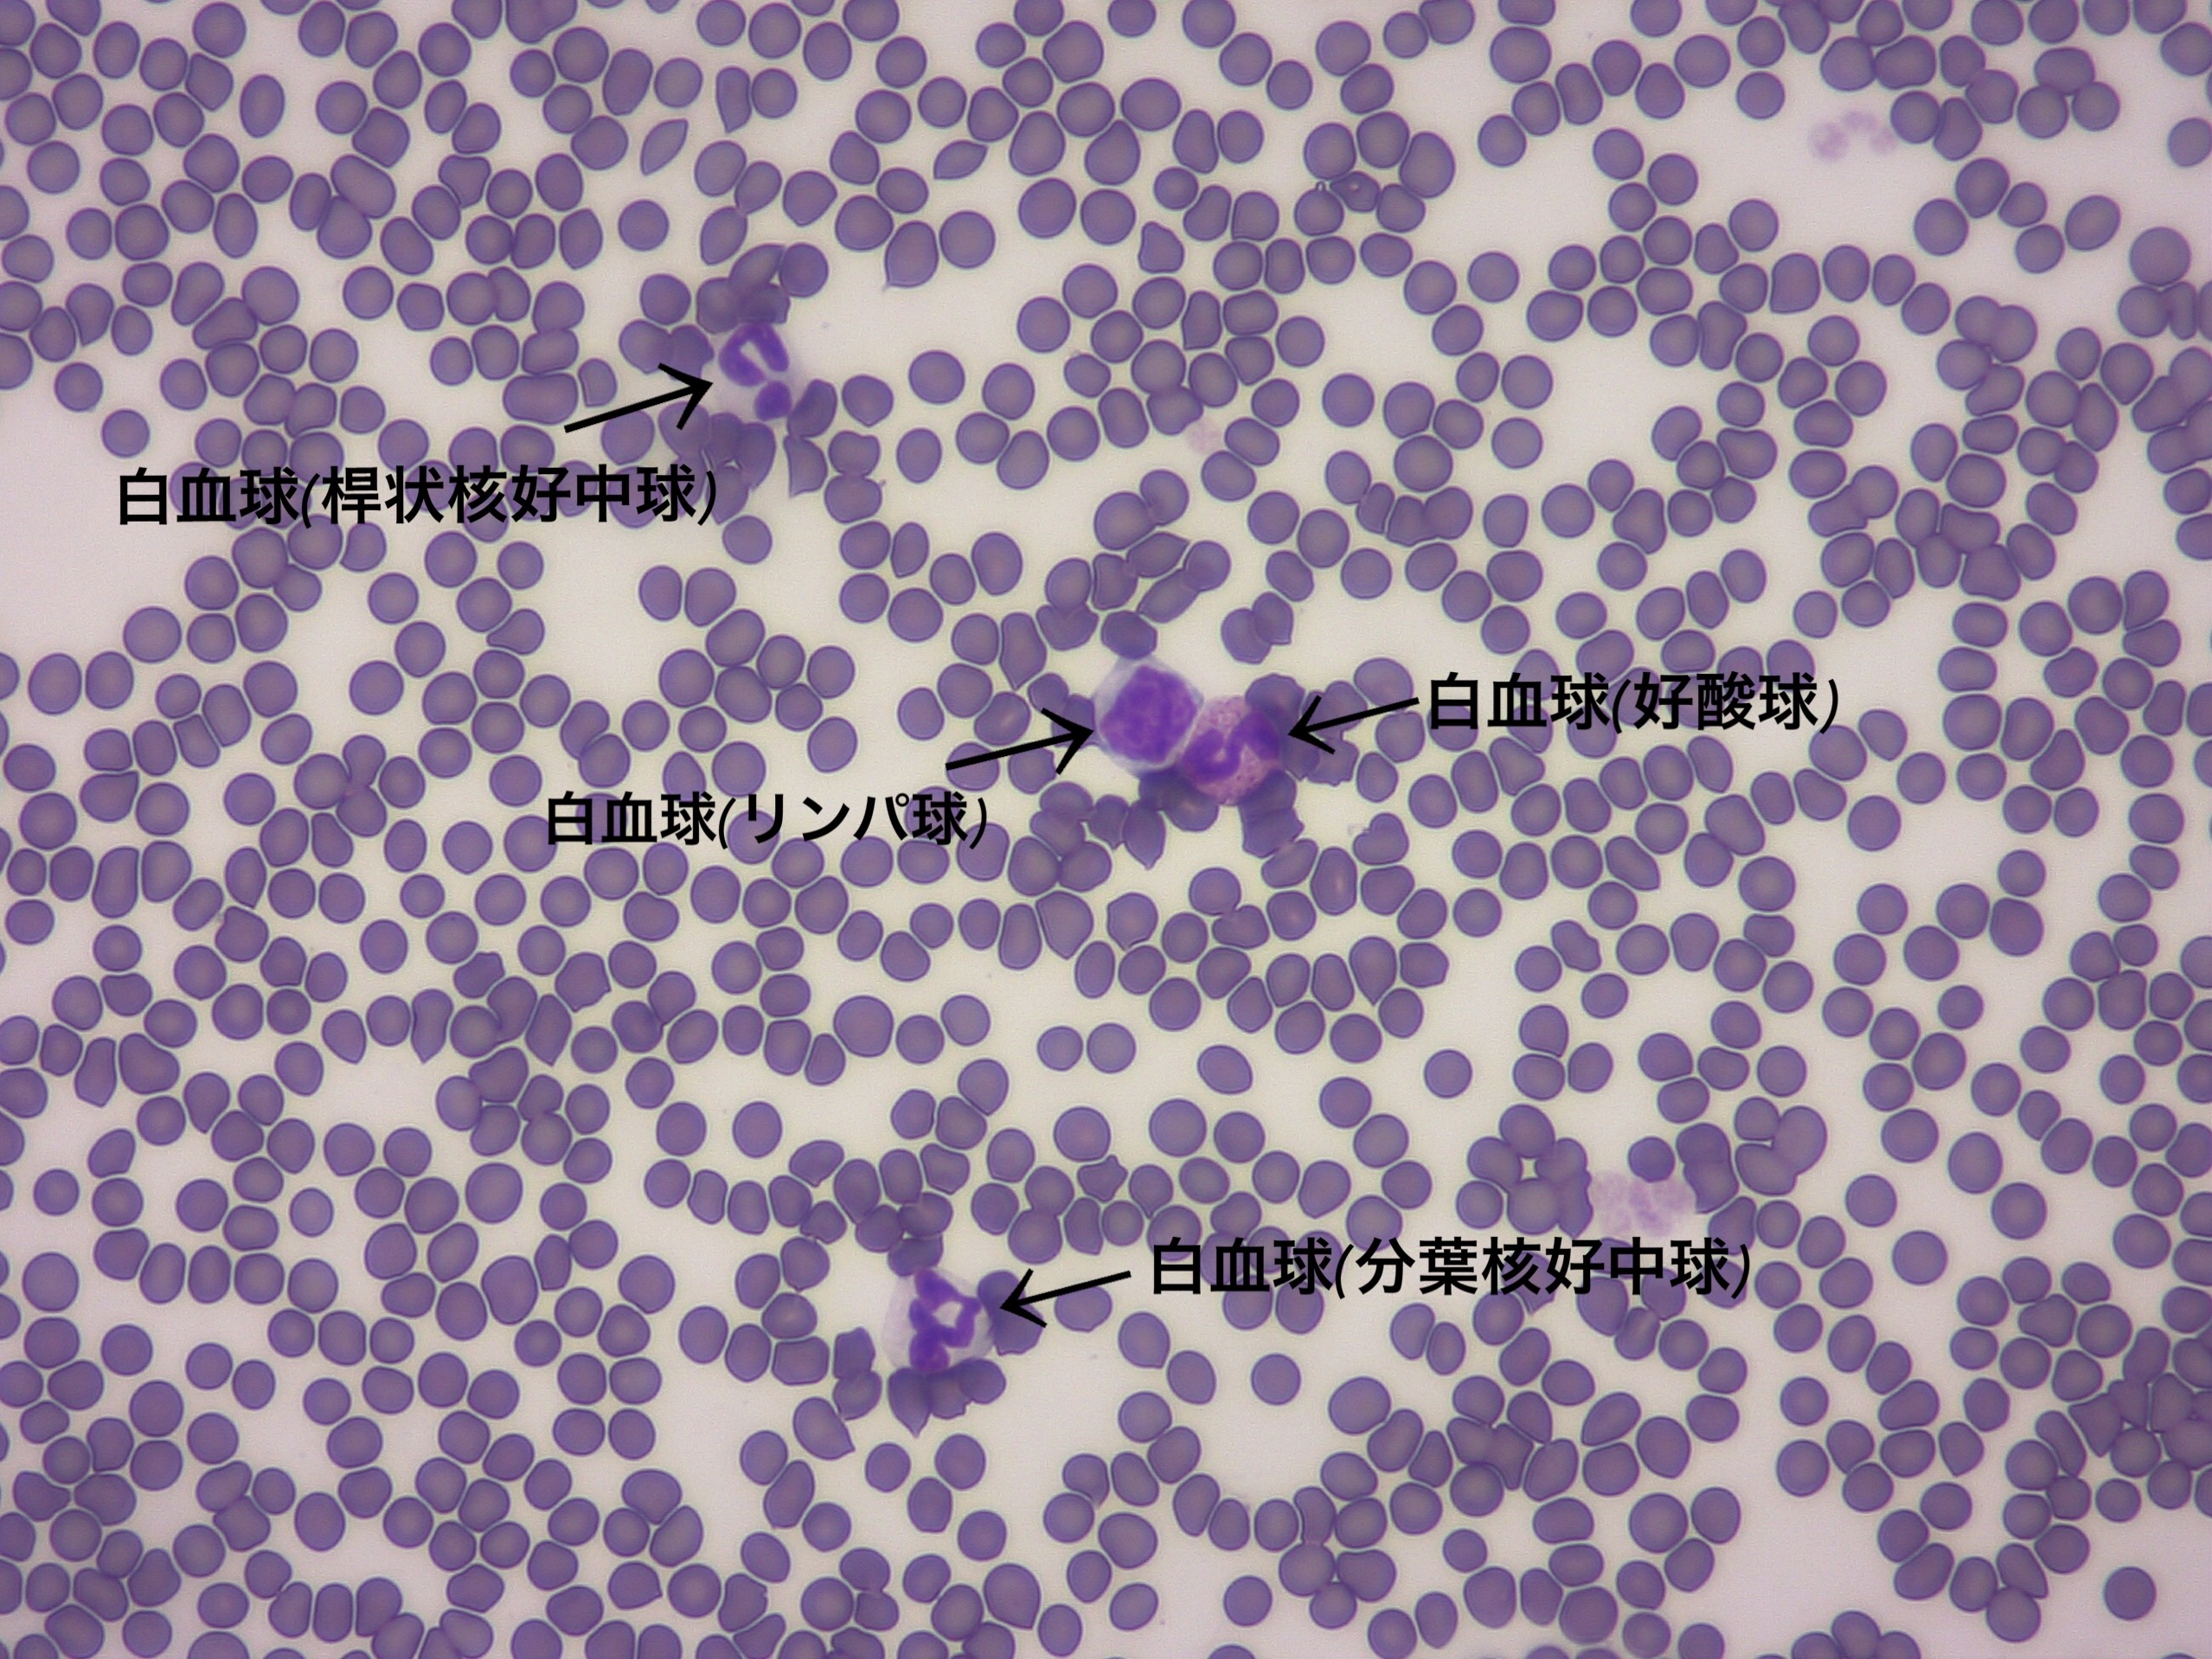
血液塗沫の顕微鏡画像

みなさんこんにちは。看護師の鈴木です。
最近寒くなってきてから家の猫のアスランがいつもの
2割ましくらいでぽふぽふになってきました笑
冬に備えて毛が生え変わったのでしょう…
見るたびにぽふぽふが増しています😂

今日は普段みなさんがあまり目にすることのない、
顕微鏡で見えるものを
写真と共にご紹介していきます。
いつもの、犬猫に関することや病気についてとは違い
今回は写真をメインでお話ししていきます☺️
顕微鏡では何を見るの?
顕微鏡は肉眼では観察できない細胞や微生物を
観察することが出来ます。
血液や骨髄、皮膚や糞便、尿など様々なものを
観察していきます。
顕微鏡で見えるもの(血液)
血液はスライドガラスに血液を引いて、
血球を観察します。
ここでは普段私たち看護師が目にすることの多い、
血球の中のごく一部のみを載せています。

細菌やウイルスなどと戦う白血球や、
酸素を運ぶ役割を持つ赤血球や、血を止める働きを
する血小板など様々な血球を判断し病気の
診断・治療に繋げています。
顕微鏡で見えるもの(皮膚)
犬猫の皮膚には常在菌と言われる、健康な体にも存在する
菌や寄生虫がいます。
それが、ブドウ球菌、マラセチア、毛包虫
(アカラス、ニキビダニ)です。
この常在菌が環境の変化や元々の体質などで増えてしまう
と皮膚病の原因になります。



ミミヒゼンダニは犬猫の耳の中に寄生するダニです。
毎月の予防薬で予防するマダニとは違い、
通常目視することは出来ず耳垢を顕微鏡で観察することで
検出されます。

顕微鏡で見えるもの(尿)
顕微鏡で尿を観察するときは、採取した尿を遠心分離し
尿沈渣を観察します。
結晶は、尿のpHによって出現する結晶の種類が異なります。
膀胱炎症状を引き起こしたり、結石を作る原因にもなります。



他にも、膀胱炎の原因にもなる細菌や
血尿があると赤血球や白血球などの血球が検出されます。
また、去勢をしていないオスの尿からは精子が検出されます。



顕微鏡で見えるもの(便)
糞便検査では主に、下痢の原因となる内部寄生虫の卵が
ないかを観察していきます。
特に野良猫は外で生活をしているため、検出されることが
多いです。




最後に
動物病院では様々な検体を顕微鏡を用いて観察します。
これからの季節、寒くなってくると飲水量が減り尿量も
減るため泌尿器の病気が多くなります。
また、猫は季節関係なく、そもそもが泌尿器の病気に
なりやすい動物です。
尿検査はオシッコだけでも検査が出来ます。
日頃からチェックをしておくと、病気が出たときに
いつごろから発症したのか、健康な時の値からどれくらい
違いがあるのかなど
判断することができます。

オシッコは排尿から3時間以内に採取して下さい。
また、採取後常温で保管する場合は6時間以内に、
すぐに持ってくるのが難しい場合は、冷蔵庫で保管し
早めに持ってきて下さい。
また、10.11.12月の期間限定で秋の健康診断も
行なっております。
この機会に、尿検査や健康診断など行ってみませんか?☺️








